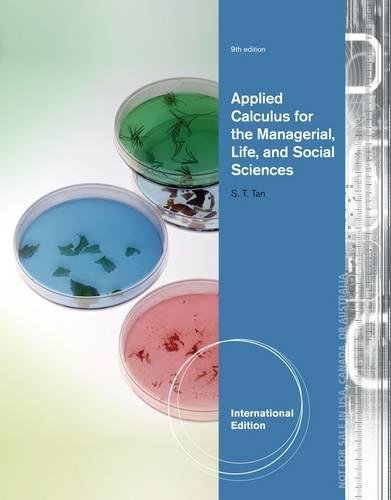

APPLIED CALCULUS FOR THE MANAGERIAL, LIFE, AND SOCIAL SCIENCES 9TH EDITION
APPLIED CALCULUS FOR THE MANAGERIAL, LIFE, AND SOCIAL SCIENCES 9TH EDITION
Couldn't load pickup availability
Soo Tan's APPLIED CALCULUS FOR THE MANAGERIAL, LIFE, AND SOCIAL SCIENCES, 9E, International Edition balances applications, pedagogy, and technology to provide readers with the context they need to stay motivated and interested in the material. Accessible for majors and non-majors alike, the book uses an intuitive approach that introduces abstract concepts through examples drawn from common, real-life experiences and numerous fields of interest to which readers can relate. Insightful Portfolios highlight the careers of real people and discuss how they incorporate math into their daily professional activities. Numerous exercises ensure that readers have a solid understanding of concepts before advancing to the next topic. Algebra review notes, keyed to the review chapter Preliminaries, appear where and when readers need them.
Share